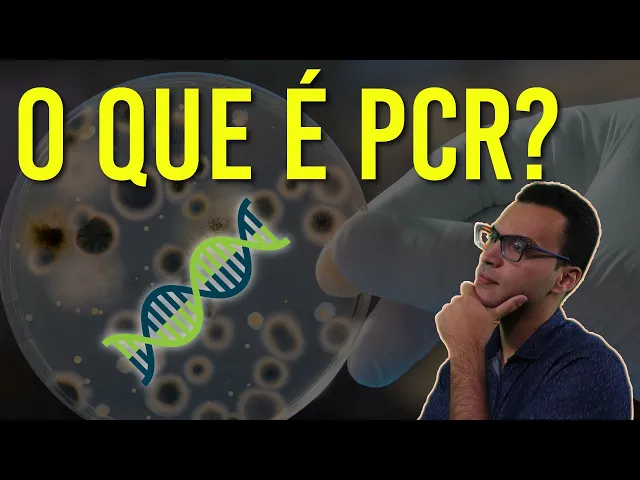

e se você acordar de manhã com febre falta de ar e tosse que são sintomas do novo coronavírus você provavelmente vai procurar uma unidade de saúde não é mesmo se essa unidade de saúde tiver estrutura mínima para fazer testes eles vão coletar uma amostra do fundo do seu nariz e enviar para um laboratório que vai fazer o teste de pcr nesse teste a mostra que pode ou não conter o vírus é processada e o material genético daquele suposto coronavírus vai ser exposto a uma reação química que mudou a história da biologia molecular e da humanidade
a reação em cadeia da polimerase essa técnica é tão revolucionária que ela permite amplificar rna ou dna só as moléculas base do genoma de qualquer organismo e obter bilhões de cópias a partir de uma amostra e isso faz com que a gente consiga de fato ver se naquela moto testada havia uma única partícula de material genético inicialmente nanoscópica mas que após a amplificação se tornou detectável e sem entrar muito em detalhes de como essa técnica funciona eu vou te contar como na década de 80 um cientista curioso chamado kell e nos presenteou com a pcr
que hoje nos permite vislumbrar onde a pandemia de coronavírus está fazendo seus pacientes infectados e vítimas sejam bem-vindos ao a ciência fontes termais e gays eles podem não ser os primeiros lugares que você olharia buscando forma de lutar quando uma pandemia mas foi nesses ambientes extremos que conseguimos a ferramenta para identificar rastrear e entender uma infinidade de patógenos na verdade se essas fontes termais não tivessem sido observadas com cuidado a biologia molecular ainda estaria presa na década de 60 mas para entender isso precisamos voltar aos anos 50 quando a pcr ainda estava nos seus primórdios
em toda a comunidade científica tava completamente vislumbrada por ter visto pela primeira vez a estrutura do dna e já pensando em mil maneiras de como ler o código genético de cada organismo por meio do sequenciamento sequenciamento que consiste de literalmente ler letra por letra do código genético nessa época era muito prematuro e depende de uma série de reações químicas que cortavam dna em pequenos pedacinhos que eram então avaliados individualmente até se obter o código de uma parte minúscula de dna só para ter ideia do quanto demorava depois da detecção da estrutura do dna 1953 só
em 1965 robert rola e conseguiu sequenciar uma pequena parte do genoma das saccharomyces cerevisiae que hoje é utilizada na fabricação de cerveja a grande dificuldade do sequenciamento estava relacionada ao fato de que era muito difícil obter cópias de dna suficientes afinal cada célula só possui uma cópia do genoma concomitante as tentativas de desenvolver o sequenciamento cientistas identificaram em 1957 a primeira dna polimerase uma enzima que fazer exatamente que todo mundo precisava pegava nucleotídeos as letrinhas do dna e completava as cadeias de dna bastava uma única fita de dna como molde e uma segunda fita incompleta
para dna polimerase desesperada e até a fita com a falta de nucleotídeos e completá-la essa enzima existe no corpo de todos os organismos é certo na grande maioria dos vírus que dependem da maquinaria celular do hospedeiro para fazer cópias do seu próprio material genético é a enzima dna polimerase que faz cópias dos genomas das células permitindo com que elas se multipliquem e exatamente nesse momento e quando você assistir esse vídeo suas dna-polimerases estão multiplicando o seu dna na pele no intestino do seu corpo todo pesquisadores logo descobriram que eles podiam isolar unidade de dna polimerase
da bactéria é cole e utilizar enzima para multiplicar cópias de dna in vitro ou seja e multiplicar uma única cópia de dna de uma amostra mas existirão obstáculos antes da dna polimerase começar a copiar o dna a dupla fita do dna encontrado em células de todos os organismos precisava ser separado em duas fitas daí reagente chamados primer se ligam a cada uma das fitas indicam para dna polimerase onde é que ela deve começar a copiar o dna no nosso corpo todo esse processo de quebrar a fita ligar primer é feito por uma série de enzimas
e proteínas mas em vidro nós não temos como adicionar tudo isso a reação mas ainda existe uma maneira de separado em vidro basta aquecer a amostra a 90° e o dna simplesmente diz natura literalmente se quebra em duas fitas diferentes então você pode esquentar a mostra a 90° para obter as fitas simples e depois esfriar a amostra para permitir a ligação dos primers permitindo assim a ação da dna polimerase depois de cada ciclo de aquecimento e resfriamento você dobra o dna na mostra porque duas fitas viram 44 viram 88 16 e assim por diante hoje
cada um desses ciclos dura em torno de três minutos então em algumas horas a gente consegue transformar uma única cópia de dna em milhões de cópias só que lá nos anos 60 o processo durava bem mais do que isso que os 90 graus que desnaturam o dna também desnaturam a dna polimerase da école então nas primeiras análises de pcr era preciso adicionar dna polimerase a cada ciclo o que encarecia demais o processo e o tornava muito demorado e chato não é mesmo imagina a cada ciclo ter que abrir a máquina abrir a amostra interpretar de
novo a dna polimerase nova e é aqui que entram as fontes termais e bactérias que conseguem sobreviver nos ambientes extremos em 1966 cientistas descobriram uma bactéria vivendo a mais de 70 graus nas piscinas termais do parque yellowstone nos estados unidos eles a chamaram de termos aqui o devido a sua habilidade de proliferar em altas temperaturas e em 1976 cientistas isolaram a sua dna polimerase e como a bactéria essa enzima também podia suportar as altas temperaturas do ambiente o que a fez perfeita para separar as fitas de dna em uma reação de pcr a 90 graus
sem precisar adicionar mais enzima a cada cinco você basicamente podia colocar a taq polimerase junto com a amostra alguns reagentes e primes e simplesmente acionar uma máquina para esquentar e esfriar gerando ciclos de amplificação seriado de dna combinando e milhões de cópias em poucas horas e isso é uma pcr que surgem na sua forma moderna a partir dos estudos de carol e males que inclusive ganhou o prémio nobel por isso utilizando vários estudos anteriores é claro que o processo para detectar o material genético do coronavírus é um pouco mais complicado que isso afinal esse vírus
em específico possui arrear ao invés de dna por isso é preciso adicionar uma enzima diferente para transformar primeiro o seu rna em dna antes de começar o processo de pcr tradicional mas o que você precisa levar para casa e contar para seus amigos e parentes é o seguinte se não fosse a pesquisa básica de um grupo de pesquisadores que estudaram que tipo de organismos conseguiram sobreviver em ambientes extremos como os gays eles do parque é o estômago provavelmente nós nem seríamos capazes de detectar o genoma do coronavírus em pacientes que apresentavam uma estranha síndrome respiratória
no final de dezembro 2019 ou mesmo nem seremos capazes de identificar a paternidade de um filho ou descobrir quem deixou aquele fio de cabelo na cena do crime tudo isso foi graças ao pcr ea curiosidade da ciência pessoal iria te convidar a conhecer o nosso problema de membros clicando no botão seja membro aí embaixo como youtube tá desmonetizando a maioria do conteúdo sobre o coronavírus essa é a nossa única forma de obter receita para continuar esse trabalho sério informando você e sua família sobre ciência e tudo que há de mais bonito nela não se esqueça
então de clicar no gostei aí se inscrever no canal e agora sim um grande abraço e até a próxima a

![Tudo sobre Proteína C-reativa (PCR) [VEJA AQUI]](https://img.youtube.com/vi/SgWxdz_GI4A/maxresdefault.jpg)






